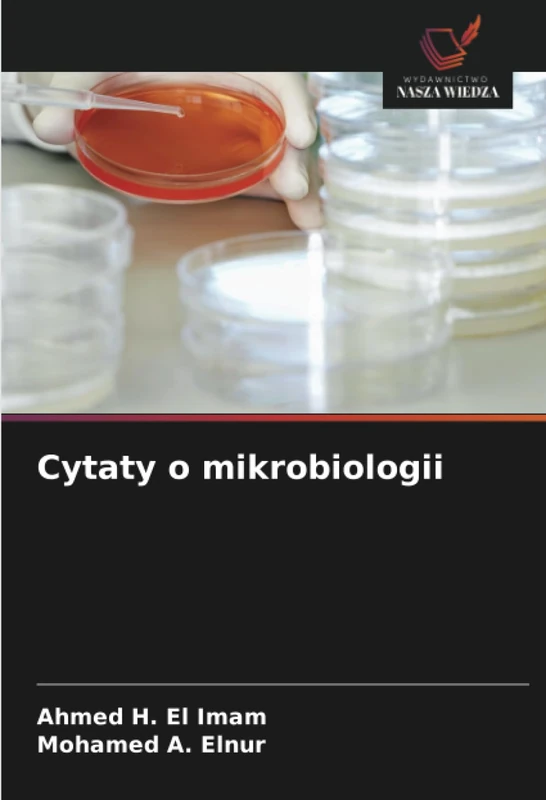
Cytaty o mikrobiologii

We can't find the internet
Attempting to reconnect
Something went wrong!
Hang in there while we get back on track

£69.00
MCQ w chemii farmaceutycznej
Price data last checked 56 day(s) ago - refreshing...
We'll watch every seller, every day. One email when your price arrives.
It has never been this cheap. We have no record of a lower price.
£69 today · cheaper than every other day in the last 3 months
NEW HERE?
Amazon shows you one price. We show you all of them.
Tosheroon watches Amazon prices so you don't have to. Every product on Amazon has a price history — we make it visible. Set the price you'd actually pay, and we'll email you the second it gets there. No app, no account, one email.
WHAT'S ON THIS PAGE
when this has been cheap or pricey
where the price is heading next
all-time high & low, recent range
name your number, we'll email you
Price History & Forecast
Grey patches = out of stock. Cheaper = lower on the chart. Hover for exact prices.
Last 35 days • 35 data points (No recent data available)
Price Distribution
Price distribution over 35 days • 1 price levels
Price Analysis
Most common price: £69 (35 days, 100.0%)
Price range: £69 - £69
Price levels: 1 different prices over 35 days
Product Specifications
- Format
- paperback
- ASIN
- 6202435518
- Domain
- Amazon UK
- Release Date
- 08 September 2025
- Listed Since
- 09 September 2025
Barcode
No barcode data available
Similar Products You Might Like

Kinetyka chemiczna

Chemodynamika cypermetryny: ekosystem bakłażana

Morfosemantyka angielska
Cytaty o mikrobiologii

Biologia dla inżynierów

Marketing cyfrowy

Kwestia edukacji szkolnej dla dzieci w Botro SP/CI

OSTEOIMMUNOLOGIA W CHOROBACH PRZYZĘBIA

MODELOWANIE MATEMATYCZNE
METODOLOGIA BADAŃ

Polimorfizm genów w mikroorganizmach

Ramy metodologiczne nauczania historii specjalistycznej

Cywilnoprawne ramy cyfryzacji gospodarki

Pulsacyjne dawkowanie

Metody Chromatograficzne WskazujĄce Na StabilnoŚĆ: DLA TOLPERISONU I DIKLOFENAKU

Bankowość i finanse

Przewodniki chirurgiczne

Zaawansowana biochemia medyczna

Klasyfikacja etiologii wad zgryzu

Badania molekularne nad wirusem pryszczycy w Egipcie

Proces programowania nauczania w edukacji

Inżynieria transportu

Odbudowa duszy Syrii
